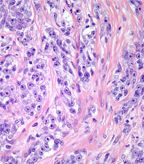

Adjuvant Chemo Regimen Fails to Extend Survival in Resected Soft-Tissue Sarcoma
Treating resected grade II-III soft-tissue sarcoma with an adjuvant chemotherapy regimen of doxorubicin, ifosfamide, and lenograstim did not result in any increase in relapse-free survival or overall survival.
Treating resected grade II-III soft-tissue sarcoma with an adjuvant chemotherapy regimen of doxorubicin, ifosfamide, and lenograstim did not result in any increase in relapse-free survival or overall survival, according to the results of the EORTC 62931 trial published online earlier this month in the Lancet Oncology.
Micrograph of clear cell sarcoma. The tumor cells have prominent nucleoli and clear cytoplasm. They are arranged in well-defined nests surrounded by dense fibrous stroma; source: Jerad M Gardner, MD
Prior research had shown that a similar treatment regimen of doxorubicin, ifosfamide, and molgramostim improved response rates in advanced sarcoma.
“The trial was done in the hope of showing that adjuvant chemotherapy would improve the survival of sarcoma patients after surgery, but it did not,” said Penella Woll, PhD, of the University of Sheffield, Sheffield, United Kingdom.
Woll and colleagues conducted a multicenter clinical trial that included patients with soft-tissue sarcoma with no lymph node involvement or metastases. Patients were aged between 16 years and 70 years and had undergone resection within 4 weeks of treatment.
Between February 1995 and December 2003, 351 patients from 36 centers in 13 countries were randomly assigned to no chemotherapy or to adjuvant treatment with five cycles of doxorubicin 75 mg/m2, ifosfamide 5 g/m2, and lenograstim every 3 weeks. Patients in both groups received radiation if the resection had marginal lines or if the tumor recurred.
At follow-up, no significant difference was seen between the chemotherapy group and the control group for overall survival (HR = 0.94; 95% CI, 0.68-1.31) or relapse-free survival (HR = 0.91; 95% CI, 0.67-1.22).
To help to put these new data in context, the researchers used the data from this study to conduct a meta-analysis with data from three prior studies of doxorubicin-based adjuvant chemotherapy. The results, according to Woll, hint “that some patients may benefit from adjuvant chemotherapy.”
Specifically, the researchers postulate that patients with larger, high-grade, limb tumors are most likely to benefit. However, an individual patient data meta-analysis will be required to confirm this, Woll said.
Woll and colleagues also pointed out several weaknesses associated with their study. Because sarcomas are rare, the recruitment for the trial was slow, the researchers wrote in their discussion.
“Some patients were excluded because their radiation oncologist was uncomfortable with delaying postoperative radiotherapy until the end of chemotherapy, others because of unresolved postoperative conditions,” they wrote. “For every patient, the decision to participate was difficult, because the treatment groups were very different and standard practice differed worldwide.”
In an editorial that accompanied the article, David D’Adamo, MD, PhD, said that this new research was an important contribution to current knowledge of adjuvant therapy in sarcoma, as it is the largest study of adjuvant therapy done to date. However, he also pointed out several weaknesses of the study, including that patients with tumors less than 5 cm were included, and the lower dose of ifosfamide used.
“The lesson from this and other studies should not be to give up on adjuvant therapy altogether, but to follow the leads from our colleagues in other disciplines such as breast and lung cancer, for which careful attention to selection of patients, dose, duration, sequence, and choice of drugs has led to stepwise increases in cure,” said D’Adamo, of the Center for Sarcoma and Bone Oncology, Dana-Farber Cancer Institute. “We look forward to the day when better agents are available for sarcoma therapy. Pazopanib has just been approved by the FDA for sarcoma in the salvage setting and trials for this agent as adjuvant therapy are planned.”
Sarcoma Awareness Month 2023 with Brian Van Tine, MD, PhD
August 1st 2023Brian Van Tine, MD, PhD, speaks about several agents and combination regimens that are currently under investigation in the sarcoma space, and potential next steps in research including immunotherapies and vaccine-based treatments.